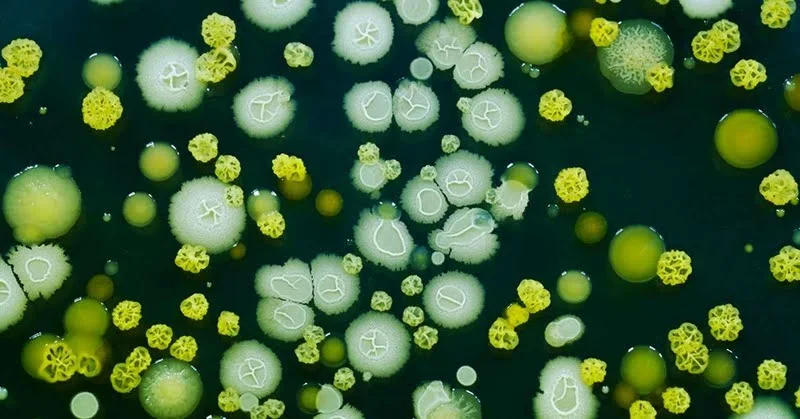

Animals,208,Birds,40,Cats,173,Cows,1,Dogs,348,Featured,14,Features,61,Fostering,1,Habits,1,Horses,1,Koala,2,Monkey,2,News,3,Panda,3,Penguin,6,Pet Care,34,Pets,130,Rabbits,1,Red Panda,1,Squirrel,4,Wildlife,1,
ltr
item
Pets | Pet Adoption, Pet Care, Pet Health, Food, Toys and More: 7 Immortal Animals That Can Basically Live Forever
7 Immortal Animals That Can Basically Live Forever
These lucky creatures have found the fountain of youth.
https://blogger.googleusercontent.com/img/b/R29vZ2xl/AVvXsEiRMNByPQiHTheDWtpVbMPyFZZTqG8Q4q1so4NnHL380HdrO5DIGqAkwM8hANYR66CmGw1YHgf8PSgjbT5FKm59B6Vvm909L7m52lR9gQo7rTegJxWbXjtifi4mN6J9zhCIH40bCs3ls-i4/s1600/6.bmp
https://blogger.googleusercontent.com/img/b/R29vZ2xl/AVvXsEiRMNByPQiHTheDWtpVbMPyFZZTqG8Q4q1so4NnHL380HdrO5DIGqAkwM8hANYR66CmGw1YHgf8PSgjbT5FKm59B6Vvm909L7m52lR9gQo7rTegJxWbXjtifi4mN6J9zhCIH40bCs3ls-i4/s72-c/6.bmp
Pets | Pet Adoption, Pet Care, Pet Health, Food, Toys and More
https://pets.dearjulius.com/2020/06/7-immortal-animals-that-can-basically-live-forever.html
https://pets.dearjulius.com/
https://pets.dearjulius.com/
https://pets.dearjulius.com/2020/06/7-immortal-animals-that-can-basically-live-forever.html
780598715723239276
UTF-8